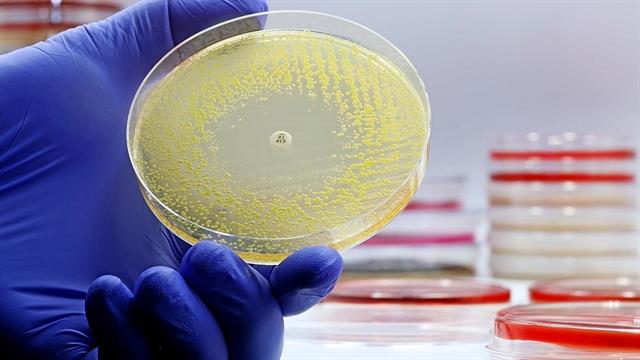
Ανακαλύφθηκε αντιβιοτικό κατά των ανθεκτικών μυκητιασικών λοιμώξεων και βακτηρίων

Κινέζοι φαρμακοποιοί ανακάλυψαν ένα νέο μακρολιδικό αντιβιοτικό που έδειξε ευρύ φάσμα δράσης κατά μυκήτων ανθεκτικών σε άλλα αντιβιοτικά σε αρχικές εργαστηριακές δοκιμές. Αναστέλλεται επίσης η ανάπτυξη βακτηριακών παθογόνων διαφυγής.
Λόγω ενός ανεξάρτητου μηχανισμού δράσης, το νέο αντιβιοτικό θα μπορούσε να χρησιμοποιηθεί και για τα σημερινά προβληματικά μικρόβια, ιδίως καθώς η τοξικότητά του φαίνεται να είναι χαμηλή σύμφωνα με τα αποτελέσματα που δημοσιεύονται στο "Nature".
Εκτός από το γνωστό πρόβλημα με τα βακτήρια, αρκετοί παθογόνοι για τον άνθρωπο μύκητες έχουν επίσης αναπτύξει ανθεκτικότητα στα αντιβιοτικά τα τελευταία χρόνια. Ένα παράδειγμα είναι οι παραλλαγές του Candida auris με μειωμένη ευαισθησία και στις 4 ομάδες αντιμυκητιασικών (πολυένια, αζόλες, εχινοκανδίνες και 5-φλουκυτοσίνη).
Καθώς τα περισσότερα αντιβιοτικά έχουν βρεθεί σε βακτήρια ή μύκητες, οι ερευνητές του Κεντρικού Εργαστηρίου Φυσικών Φαρμάκων του Πανεπιστημίου Nanjing ξεκίνησαν την αναζήτηση νέων δραστικών συστατικών στη φύση.
Ωστόσο, δεν περιπλανήθηκαν στα λιβάδια και τα δάση απομακρυσμένων περιοχών.
Το σημείο εκκίνησης ήταν η έρευνα μέσω υπολογιστών. Οι ερευνητές ανέλυσαν τις αλληλουχίες περισσότερων από 310.000 βακτηριακών γονιδιωμάτων.
Μεταξύ των 1,78 εκατομμυρίων τμημάτων γονιδίων που κωδικοποιούν πρωτεΐνες, αναζήτησαν συγκεκριμένα τις γενετικές οδηγίες για μόρια που επιτίθενται στην κυτταρική μεμβράνη των μυκήτων, όπως τα αντιμυκητιασικά πολυένια. Ανάμεσα σε 280 ομάδες βιοσυνθετικών γονιδίων, βρήκαν τελικά ένα μακρολίδιο που χρησιμοποιεί με επιτυχία ο Streptomyces netropsis για να αμυνθεί κατά των μυκήτων.
Σε μικροβιολογικές δοκιμές, αυτό το μακρολίδιο, που οι ερευνητές ονόμασαν μαντιμυκίνη, δεν ήταν αποτελεσματικό μόνο κατά των πολυανθεκτικών μυκήτων Candida και Cryptococcus neoformans και Aspergillus fumigatus, οι οποίοι μπορεί να είναι επικίνδυνοι για τους ανοσοκατεσταλμένους ασθενείς.
Η μαντιμυκίνη θα μπορούσε επίσης να είναι αποτελεσματική κατά των πολυανθεκτικών βακτηρίων Eskape, τα οποία εμφανίζονται συχνά σε νοσοκομειακές λοιμώξεις. Δεν ήταν ανιχνεύσιμη βακτηριοκτόνος δράση κατά των Gram-θετικών ή Gram-αρνητικών παθογόνων μικροοργανισμών.
Οι ερευνητές αποδίδουν την επίδραση στους ανθεκτικούς μικροοργανισμούς σε διαφορετικό μηχανισμό δράσης. Τα περισσότερα άλλα αντιμυκητιασικά δεσμεύονται στην εργοστερόλη ή αναστέλλουν τη σύνθεση αυτού του δομικού στοιχείου στην κυτταρική μεμβράνη των μυκήτων. Η μαντιμυκίνη, από την άλλη πλευρά, σχηματίζει σύμπλοκα με τα φωσφολιπίδια της μεμβράνης. Αυτό αυξάνει τη διαπερατότητα για τα ιόντα. Το αποτέλεσμα είναι η κατάρρευση των κυττάρων του μύκητα.
Η μαντιμυκίνη έχει αποδειχθεί μη τοξική και εξαιρετικά αποτελεσματική σε αρχικές μελέτες σε ζώα. Σε αντίθεση με την αμφοτερικίνη Β, η μαντιμυκίνη δεν φαίνεται να βλάπτει τους νεφρούς και δεν παρατηρήθηκε αιμόλυση ακόμη και σε υψηλές δόσεις.
Τα ποντίκια προστατεύονταν αξιόπιστα από διεισδυτική λοίμωξη Candida σε υψηλότερη δόση, η οποία ήταν πάντα θανατηφόρα στην ομάδα ελέγχου.
Η μανδιμυκίνη αποδείχθηκε αποτελεσματική σε λοιμώξεις μαλακών μορίων με πολυανθεκτικά φάρμακα C. albicans, C. auris και C. neoformans και θεράπευσε δερματικές και κολπικές μυκητιασικές λοιμώξεις.
Λόγω των πολυάριθμων αλυσίδων σακχάρων, η μαντιμυκίνη είναι υδατοδιαλυτή και, επομένως, επίσης διαθέσιμη από το στόμα, γεγονός που θα μπορούσε να διευκολύνει τη θεραπεία στα εξωτερικά ιατρεία.
Η επιβεβαίωση από άλλες ερευνητικές ομάδες εξακολουθεί να λείπει. Επομένως, δεν είναι σαφές εάν η μαντιμυκίνη μπορεί να καλύψει το θεραπευτικό κενό που προκύπτει από τον αυξανόμενο αριθμό ανθεκτικών μυκητιασικών λοιμώξεων.
Πηγές:
Deutsches Ärzteblatt
Ειδήσεις υγείας σήμερα
Μπορούν τρόφιμα να ενισχύσουν την απορρόφηση της βιταμίνης D;
Ημέρα του Πατέρα: Διατροφικές επιλογές για καλύτερη υγεία
Πρωινές συνήθειες που βοηθούν στη δυσκοιλιότητα
Τα φυτά "φρενάρουν" το ανοσοποιητικό τους για να επιβιώσουν από τις ιογενείς λοιμώξεις
Τα φυτά "φρενάρουν" το ανοσοποιητικό τους για να επιβιώσουν από τις ιογενείς λοιμώξεις Διαβήτης: Οι λοιμώξεις αποτελούν σημαντικό κίνδυνο [μελέτη]
Διαβήτης: Οι λοιμώξεις αποτελούν σημαντικό κίνδυνο [μελέτη] Φυσική κατάσταση και παλμοί της καρδιάς επηρεάζουν την εκδήλωση Long CοViD
Φυσική κατάσταση και παλμοί της καρδιάς επηρεάζουν την εκδήλωση Long CοViD Η μικρορευστομηχανική αντιμετωπίζει τις ανθεκτικές λοιμώξεις - Πώς λειτουργεί
Η μικρορευστομηχανική αντιμετωπίζει τις ανθεκτικές λοιμώξεις - Πώς λειτουργεί ECDC: Οδηγίες για έλεγχο λοιμώξεων από τον ιό 'Εμπολα σε υγειονομικούς χώρους της Ευρώπης
ECDC: Οδηγίες για έλεγχο λοιμώξεων από τον ιό 'Εμπολα σε υγειονομικούς χώρους της Ευρώπης Ι. Καβαλιώτης: Αποχαιρετισμός σε έναν δάσκαλο των παιδιατρικών λοιμώξεων
Ι. Καβαλιώτης: Αποχαιρετισμός σε έναν δάσκαλο των παιδιατρικών λοιμώξεων Μπορούν τρόφιμα να ενισχύσουν την απορρόφηση της βιταμίνης D;
Μπορούν τρόφιμα να ενισχύσουν την απορρόφηση της βιταμίνης D; Ημέρα του Πατέρα: Διατροφικές επιλογές για καλύτερη υγεία
Ημέρα του Πατέρα: Διατροφικές επιλογές για καλύτερη υγεία Πρωινές συνήθειες που βοηθούν στη δυσκοιλιότητα
Πρωινές συνήθειες που βοηθούν στη δυσκοιλιότητα Βρώμη και κινόα: Πώς συγκρίνονται από άποψη πρωτεΐνης
Βρώμη και κινόα: Πώς συγκρίνονται από άποψη πρωτεΐνης Ρύζι, πατάτες και ζυμαρικά: Ποιο είναι χειρότερο για το σάκχαρο;
Ρύζι, πατάτες και ζυμαρικά: Ποιο είναι χειρότερο για το σάκχαρο; Με ποιες τροφές να συνδυάζω ρύζι, πατάτες και ζυμαρικά για να μην αυξάνεται απότομα το σάκχαρο
Με ποιες τροφές να συνδυάζω ρύζι, πατάτες και ζυμαρικά για να μην αυξάνεται απότομα το σάκχαρο Pharmathen: Βαθιά κρίση και μηδενισμός αποτίμησης από funds της Partners
Pharmathen: Βαθιά κρίση και μηδενισμός αποτίμησης από funds της Partners Καρπούζι: Ποια είναι τα οφέλη του στην υγεία
Καρπούζι: Ποια είναι τα οφέλη του στην υγεία Ισχυρή πρωτιά της ΔΗΚΙ στις εκλογές του Ιατρικού Συλλόγου Αθηνών - Ρεκόρ συμμετοχής
Ισχυρή πρωτιά της ΔΗΚΙ στις εκλογές του Ιατρικού Συλλόγου Αθηνών - Ρεκόρ συμμετοχής Ιατρικός Σύλλογος Θεσσαλονίκης: Σαρωτική επικράτηση της ΕΝΟ.ΣΥ. - Ν.Ι.Κ.Ι.
Ιατρικός Σύλλογος Θεσσαλονίκης: Σαρωτική επικράτηση της ΕΝΟ.ΣΥ. - Ν.Ι.Κ.Ι. Φαρμακοβιομηχανίες σκέφτονται να χτυπήσουν την πόρτα της Εθνικής Αρχής Διαφάνειας
Φαρμακοβιομηχανίες σκέφτονται να χτυπήσουν την πόρτα της Εθνικής Αρχής Διαφάνειας Οι απρόσμενες συνέπειες της ολοκληρωτικής παράλειψης της ζάχαρης από τη διατροφή [μελέτη]
Οι απρόσμενες συνέπειες της ολοκληρωτικής παράλειψης της ζάχαρης από τη διατροφή [μελέτη]